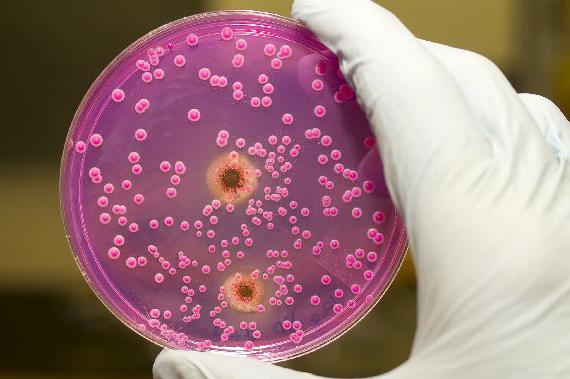
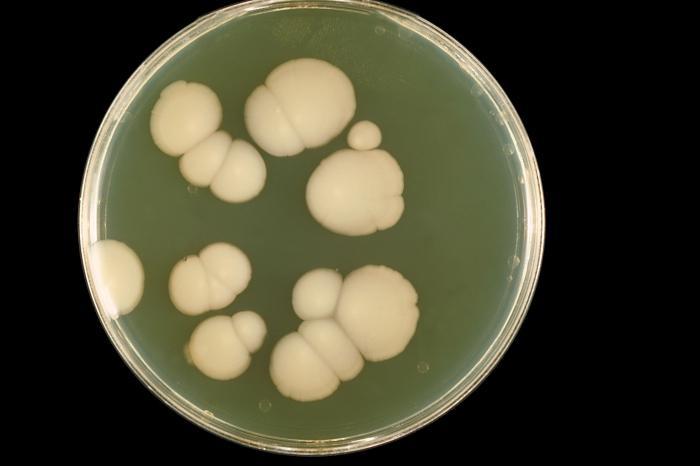

Кандидоз желудка – достаточно распространенное заболевание, спровоцированное активностью грибковой инфекции рода Candida. Условно-патогенные микроорганизмы в небольших количествах присутствуют в организме каждого человека (ротовой полости, толстой кишке, влагалище).
Причины ослабления иммунитета
Иммунный статус человека может ослабнуть при:
- затяжных инфекционных болезнях и сахарном диабете,
- наличии злокачественных образований,
- различного рода травмах,
- длительном лечении антибиотиками,
- неблагоприятном социально-экономическом положении.
Не последнюю роль играет возрастной фактор: чаще всего кандидозом желудка болеют люди преклонного возраста и дети. Риску поражения грибковой инфекцией также подвергаются люди, у которых обнаружен СПИД, онкология, сахарный диабет, хронические болезни щитовидной железы, почек, пищевода, кишечника, желудка. При внутренних кровотечениях либо раковой опухоли грибы Candida могут прорастать сквозь стенки пораженного органа, провоцируя тем самым угрожающие жизни последствия.
Пути заражения кандидозом ЖКТ
Местом локализации кандидозной инфекции чаще всего является желудок, куда грибок проникает естественным путем: через ротовую полость, по пищеводу. Заражение болезнью может происходить несколькими способами:
- при контакте с загрязненными предметами (грязные вещи, плохо вымытые овощи, фрукты);
- в процессе родов – от зараженной матери младенцу,
- от больного человека здоровому воздушно-капельным путем.
Симптом кандидоза желудка
Определить наличие грибка Candida в желудке можно по следующим симптомам:
- Болевые ощущения в эпигастральной области. Для ее определения следует мысленно нарисовать на животе треугольник, расположив его основание под ребрами на уровне пупка; вершина смыкается в области ребер. Участок тела внутри треугольника и есть эпигастральная область.
- Тошнота и рвота. При этом часто в рвотных массах путем проведения лабораторных исследований можно обнаружить частицы гриба, которые визуально выглядят как творожистые пленки и прожилки крови. Данные признаки указывают на воспаление слизистой оболочки желудка.
Кандидоз, симптомы которого выражаются болью в области живота, может осложниться прободением стенки органа с ее разрушением, внутренним кровотечением и возможным развитием перитонита. Кровотечение может проходить незаметно, пока не разовьется железодефицитная анемия. При крупном разрушении сосуда существует угроза жизни.
Кандидоз кишечника и пищевода
Кандидоз пищевода (иначе — кандидозный эзофагит) сопровождается:
- изжогой, жжением в области глотки — данные признаки появляются не сразу, а спустя 2-3 недели с начала болезни;
- появлением во рту белого налета с неприятным запахом.
- затруднением глотания (в тяжелой форме) по причине перекрытия просвета пищевода кандидозными пленками.
Поражение кишечника грибками Candida можно предполагать по появившемуся дискомфорту в области живота, болевых ощущениях, диарее. В жидком стуле присутствует слизь, примеси крови, творожистые включения.
Общими признаками для вышеперечисленных видов кандидоза является:
- слабость, сонливость, недомогание,
- снижение трудоспособности,
- потеря аппетита,
- повышенная температура тела.
Диагностика заболевания желудка
Более быстрый результат выявления возбудителя можно получить методом полимеразной цепной реакции (ПЦР). Антитела к грибкам Кандида позволяет выявить проведение иммунологических реакций.
При подозрении на кандидоз пищевода и желудка с целью выявления нитей грибов лабораторным путем проводится исследование каловых и рвотных масс больного. Лечение назначается после точной постановки диагноза.
Лечение кандидоза ЖКТ
Важным фактором успешного избавления от кандидозной инфекции является своевременная терапия, не дающая спорам гриба распространиться далее, в глубокие слои стенок пищеварительных органов.
Препараты для симптоматической терапии:
Дозировка и продолжительность лечения назначается врачом; самостоятельно лечить кандидоз желудка аптечными препаратами не рекомендуется. При легком течении болезни лечение можно проводить амбулаторно, в сложных случаях – в стационаре.
Диета
Обязательным фактором успешного лечения является правильная организация питания: дробное, обогащенное витаминами группы А, В, С, с умеренным количеством углеводов. Рекомендуется кушать побольше каш (на молоке или воде, но без сахара). С целью обеспечения благоприятного размножения полезных микроорганизмов в рацион следует включать квашеные овощи, овсяный кисель, кисломолочные продукты, сыворотки.
Народные методы против грибковой инфекции
Народная медицина предлагает лечить кандидоз ЖКТ путем употребления большого количества ягод голубики, жимолости, черники, капусты всех видов.
После приема пищи полезно будет полоскание ротовой полости содой, синим йодом либо другим противогрибковым раствором. После полоскания желательно подержать во рту зверобойное или облепиховое масло либо смазать слизистую ротовой полости и язык слизью семян льна.
Лечение кандидоза желудка народными средствами эффективно при регулярном употреблении овсяного киселя. Для приготовления требуется наполнить 3-литровую банку овсяными хлопьями.
Профилактические мероприятия
Профилактические мероприятия включают в себя устранение факторов риска, лечение болезней пищеварительного тракта, укрепление общего иммунитета. Лекарственные препараты следует принимать только под врачебным контролем; антибиотики желательно заменить препаратами более щадящего для микрофлоры действия.
Кандидоз желудка, лечение и симптомы которого указывают на необходимость соблюдения щадящей диеты, требует соблюдения правил индивидуальной гигиены, тщательного мытья овощей и фруктов, ведения здорового и активного образа жизни.
Одним из распространенных заболеваний, касающихся молочницы, является кандидоз желудка.
Причины болезни могут быть разнообразными, но это происходит в результате бесконтрольного приема антибактериальных препаратов широкого спектра действия и сниженного иммунитета.
Начинается болезнь с кишечника, после молочница постепенно распространяется на ротовую полость, желудок и пищевод.
Причины кандидоза желудка
Говоря о причинах, по которым развивается кандидоз в желудке, нужно отметить, что у здорового человека в микрофлоре имеется несколько разновидностей дрожжеподобных грибов.
Они не проявляют себя никак, так как их активность сдерживается в результате особых бактерий. В случае нарушений в работе желудка, у человека начинает развиваться кандидоз.
Основной причиной в результате которой развивается молочница в желудке является снижение уровня полезных бактерий. Происходит это в результате приема стероидных и антибактериальных препаратов.
Наблюдается ослабление барьера на пути условно-патогенных организмов, в результате споры гриба начинают активно размножаться. Иммунная система ослабевает, у нее нет сил сопротивляться инфекциям, в результате наблюдается развитие кандидоза.
Кандидоз в желудочно-кишечном тракте может возникнуть на фоне слабого иммунитета, причиной которого бывают такие факторы:
- наличие у человека ВИЧ-инфекции;
- дисбактериоз;
- перенесенное оперативное вмешательство или травмы;
- диабет и остальные болезни эндокринной системы;
- наличие доброкачественных и злокачественных образований;
- хронические патологические процессы в дыхательных органах и почках.
В зону риска заболевания молочницей кишечника и желудка входят люди пенсионного возраста. По данным статистики, примерно у ¼ населения во время проведения обследований обнаруживается грибок кандида.
Симптомы кандидоза
Если у человека есть кандидоз желудка, симптомы не всегда можно различить на начальной стадии. Примерно 1/3 больных людей не испытывают никаких признаков, которые характерны для такой болезни.
У большинства пациентов, при наличии заболевания, наблюдается дисфункция желудка, напоминающая отравление. Мало кто из больных обращается к врачу после выявления симптомов заболевания.
Если имеется кандидоз желудка, то характерными симптомами является:
- Плохой аппетит. У больного наблюдается изменение вкусовых ощущений, во рту начинает присутствовать неприятный вкус. Если грибковая инфекция перейдет в область гортани, то у больного могут возникнуть трудности с глотанием.
- Чувство тошноты, рвота с примесью крови, пленок и прожилок. В рвотных массах могут наблюдаться творожистые частички белого цвета.
- Если грибница перейдет на стенки желудка, то у больного наблюдается диарея, в каловых массах присутствует слизь и творожистые включения.
- Если кандиды поразили желудок, то у больного начинает болеть живот, подобные явления наблюдаются, если возникает эрозивный или катаральный гастрит;
- В редких случаях, при наличии кандидоза в желудке, у больного появляется повышение температуры тела. Почти во всех случаях больной ощущает снижение работоспособности, вялость, слабость.
- В некоторых случаях симптомы заболевания могут проявиться на слизистой полости рта.
Если лечение на было начато своевременно, то молочница начинает распространяться на остальные органы, кандидоз приобретает генерализованную форму, в результате чего появляется серьезная опасность для организма в целом.
Осложнения при кандидозе
Если кандидоз желудка игнорировать, не начиная своевременное лечение, то больного могут ждать весьма серьезные последствия для здоровья.
Колония грибка может начать размножаться в глотке и полости рта, вызывая в этом месте молочницу. На фоне этого у больного появляется сухой кашель, чувство жжения и сухость во рту.
Если наблюдается прободение стенок желудка, наблюдается разрушение сосудов и перитонит. Все этим проявления заболевания также сопровождаются началом внутреннего кровотечения.
В случае большой утраты крови человек испытывает железодефицитную анемию. Грибок поражает ткани мышц, становясь причиной язвенной болезни, гастрита, а в некоторых случаях и рака желудка.
Диагностика заболевания
Если у вас имеются все перечисленные выше симптомы, подтвердить, что это именно молочница способен лишь лечащий врач, на основе результатов анализов. Для диагностики потребуется взять рвотные массы или кал больного.
С помощью проведения микроскопического анализа можно увидеть наличие во взятом материале грибковых нитей. При помощи проведенного посева можно определить вид кандиды.
Для подтверждения заболевания рекомендуется пройти эндоскопию желудка взятием материала для проведения последующей биопсии. Для того чтобы лечение оказалось быстрым и эффективным рекомендуется определить не только тип грибка, но также причину, в результате которой развилась инфекция.
Во время диагностики больному рекомендуется сдать кровь на определение уровня иммуноглобулина. Если будет обнаружена нехватка антител, которые отвечают за уровень патогенных организмов, то рекомендуется начать курс иммуностимуляторов и иммуномодуляторов.
Лечение кандидоза желудка
Только врач гастроэнтеролог может назначить эффективное лечение кандидоза желудка. Необходимо проводить комплексное лечение, в зависимости от причин болезни и типа возбудителя. В том случае, если причиной кандидоза стал длительный прием антибактериальных средств, то в первую очередь нужно перестать их принимать.
При кандидозе желудка одним из эффективных средств является флуконазол. Если заболевание не находится в тяжелой форме, то этого препарата будет достаточно для лечения молочницы. Назначают средство в форме таблеток, каждый день по 100-150 мг.
Больному также могут назначить другие противогрибковые медикаменты, среди которых нужно выделить, следующие:
- Микогептин – антибактериальный препарат, выпускается в форме таблеток и желтых капсул. Рекомендуется принимать дважды в сутки после еды по две таблетки. Продолжительность лечения 10-14 дней.
- Нистатин – противогрибковый препарат, которые рекомендуется использовать при наличии кишечных грибковых инфекций. Препарат рекомендуется принимать 3-4 раза в день по 1-2 таблетки.
- Леворин – антибактериальное противогрибковое средство, выпускаемое в форме таблеток. При кандидозонисельстве и кандидозе желудка рекомендуется принимать 2-4 раза в день по 1 таблетке препарата.
Для лечения тяжелой формы заболевания больного помещают в стационар. В этом случае необходимо приложить максимум усилий для того, чтобы заболевание не перешло на остальные органы.
Если заболевание протекает в тяжелой форме, то больному делают внутривенные уколы амфотерипина либо амфолипа.
На фоне приема противогрибковых лекарственных средств рекомендуется пить пробиотики и пребиотики, с помощью которых достигается нормализации микрофлоры ЖКТ:
- линекс – средство комбинированного типа для нормализации микрофлоры кишечника, включает три типа молочных бактерий;
- хилак – капли имеющие в своем составе Lactobacillus helveticus. Рекомендуется принимать во время или до еды по 40-60 капель, растворяя в большом объеме жидкости;
- энтерол – порошок или капсулы для приготовления суспензии, имеющие в составе живые сахаромицеты буларди.
Диета при кандидозе желудка
При наличии заболевания необходимо придерживаться комплексного лечения, уделяя особое внимание диете.
При молочнице питание должно быть:
- убрать из рациона алкогольные напитки, сладости и сдобные булки;
- картофель, хлеб, нежирную отварную свинину и макароны можно употреблять в ограниченных количествах;
- ежедневно в меню должны присутствовать кисломолочные продукты (кефир, творог, йогурт), огурцы и яйца.
Вывод
В результате всего вышесказанного нужно отметить, что кандидоз желудка – болезнь, которая может вызывать осложнения без своевременного лечения. Важно диагностировать заболевание на начальном этапе, тогда лечение будет эффективным и быстрым, без вредя для здоровья.
Чем опасна молочница? Что следует ожидать от молочницы?
Кандидоз желудка – это инфекционное заболевание, причиной которого является дрожжеподобный гриб из рода Кандиды, и характеризующееся проявлениями гастрита (воспаления стенок желудка).
Заболевание распространено в развивающихся странах с теплым и влажным климатом, чаще встречается у детей и лиц пожилого возраста. Половая принадлежность на возникновение заболевания не влияет.
Причины
Кандидоз желудка в большинстве случаев развивается у лиц с ослабленной иммунной системой и при наличии кандидозного хейлита, кандидоза ротовой полости или кандидоза пищевода.
Возбудителем инфекции является гриб из рода Кандиды – это одноклеточный микроорганизм белого цвета с округлой формой.
Главным предрасполагающим фактором развития кандидоза желудка является наличие сниженного иммунитета. К такому состоянию организма ведут физиологические, генетические или приобретенные иммунодефициты:
- Физиологическиеиммунодефициты:
- период новорожденности;
- ранний детский возраст;
- пожилой возраст;
- стрессы;
- беременность и период лактации.
- Генетическиеиммунодефициты:
- синдром Ди-Джорджи (отсутствие тимуса (вилочковой железы) – которая в период новорожденности и в раннем детском возрасте отвечает за иммунную защиту организма);
- синдром Веста (недостаточность выработки иммуноглобулинов класса А);
- синдром Чедиака-Хигаши (нарушение функции нейтрофилов – клеток иммунной системы, действие которых направлено на борьбу с инфекцией);
- синдром Незелофа (нарушение функции и недостаток выработки Т-лимфоцитов – клеток иммунной системы).
- Приобретенныеиммунодефициты:
- последствия после перенесенного мононуклеоза;
- последствие онкологического процесса в организме;
- ВИЧ-инфекция;
- СПИД (синдром приобретенного иммунодефицита);
- облучение;
- ожоговая болезнь;
- трансплантация органов;
- затяжные хронические инфекции в организме, требующие длительного приема антибактериальных препаратов широкого спектра действия.
Симптомы и локализация
- слабость;
- общее недомогание;
- повышение температуры тела;
- вялость;
- снижение трудоспособности;
- снижение аппетита;
- икота;
- изжога;
- отрыжка кислым;
- боли в области желудка ноющего или режущего характера;
- вздутие кишечника;
- тошнота;
- рвота, в которой могут быть беловатые включения и небольшое количество крови;
- жидкий стул с беловатыми, творожистыми включениями.
Диагностика
Диагностика кандидоза желудка включает в себя два основных метода: микроскопическое исследование эпителия желудка и обнаружение антител к грибам из рода Кандиды в сыворотке крови.
Для получения исследуемого материала проводится ФГДС (фиброгастродуоденоскопия) – эндоскопическое исследование пищевода и желудка с выполнением биопсии – забора образца ткани желудка. Также материалом для исследования могут служить рвотные массы и кал.
Из полученного материала готовят препарат и изучают под микроскопом. Для кандидозной инфекции характерно наличие скоплений овальных белых клеток группами, на периферии которых находятся нити псевдомицелия.
Данное исследование проводится при помощи специфических аутоиммунных реакций, наиболее информативными из которых являются:
- ИФА (иммуноферментный анализ);
- РНГА (реакция непрямой агглютинации);
- ПЦР (полимеразная цепная реакция) – данный метод является самым информативным и самым дорогостоящим.
Лечение
Противогрибковые препараты:
- Микогептин по 25 000 ЕД 2 раза в сутки до еды;
- Нистатин по 1 000 000 ЕД 3 раза в сутки;
- Флуконазол по 100-150 мг 2 раза в сутки;
Симптоматическое лечение:
- при появлении изжоги — ранитидин по 1 таблетке 3 раза в день;
- при боли в желудке – омепразол или пантопрозол по 40 мг 1 раз в сутки на ночь;
- при тошноте или рвоте – церукал по 1 таблетке 2-3 раза в сутки;
- при продолжительной диарее — имодиум по 1 таблетке после каждого жидкого стула;
- при вздутии кишечника — сорбенты – энтеросгель или полисорб — по 1 столовой ложке 3 раза в сутки между приемами пищи.
Среди микозов человека лидирующие позиции занимает молочница. Ее возбудителем является грибок candida. Он относится к дрожжеподобным паразитическим грибам и поражает слизистые оболочки внутренних органов, органы желудочно-кишечного тракта не являются исключением. Симптомы кандидоза желудка (или молочницы) проявляются у четверти населения планеты, заболевание требует обязательного лечения.
Что такое кандидоз желудка
При нарушении микрофлоры кишечника паразитический гриб начинает проявлять активность. Его споры распространяются в ротовую полость, пищевод, желудок. При нормальном состоянии слизистых оболочек пищеварительных органов возникновение кандидоза невозможно. Внутренняя микрофлора выделяет противогрибковые компоненты. При наличии хронического гастрита, язвы желудка и других воспалений споры гриба попадают на пораженные участки слизистой оболочки и постепенно распространяются на здоровые.
Симптомы грибка в желудке
В отличие от других органов пищеварительной системы микоз желудка не имеет ярко выраженных симптомов. У трети пациентов они полностью отсутствуют. На симптоматику оказывают влияние локализация кандидоза, его природа, степень поражения, индивидуальные особенности организма. Кандидоз желудочно-кишечного тракта путают с гастритом, язвой двенадцатиперстной кишки, пищевым отравлением, поэтому у большинства пациентов начало лечения приходится на поздние стадии развития заболевания.
Определить поражение слизистой оболочки желудка паразитическим грибом можно не только по фото больного органа, но и по следующим симптомам и состояниям:
- изменение вкусовых ощущений;
- неприятный запах изо рта;
- плохой аппетит;
- трудности с глотанием;
- нарушение кислотности желудка;
- внутренние кровотечения;
- тошнота, рвота;
- в рвотных массах присутствуют кровянистые вкрапления, пленки, творожистые частички;
- диарея;
- в каловых массах отмечается наличие слизи, творожистых включений;
- появляются болевые ощущения в желудке;
- редко фиксируется повышение температуры тела;
- снижение работоспособности;
- общая слабость.
Причины
На фоне снижения иммунитета, при наличии воспалений, развитие молочницы становится бесконтрольным и наносит вред организму. Грибок желудка активно размножается по таким причинам:
- наличие язвы, гастрита, других болезней ЖКТ;
- омертвение и повреждение слизистых оболочек внутренних органов;
- инфицирование ВИЧ;
- наличие дисбактериоза;
- перенесенная операция;
- травмы;
- диабет и другие эндокринные нарушения;
- новообразования злокачественного и доброкачественного характера;
- хронические патологии органов дыхания и почек;
- длительное бесконтрольное употребление антибиотиков и других лекарственных препаратов, которые приводят к нарушению флоры.
Пути заражения кандидозом ЖКТ
Грибы рода Кандида являются постоянными обитателям организма человека и относятся к условно-патогенным микроорганизмам. Первичное инфицирование происходит еще на стадии внутриутробного развития, далее споры гриба через пищевод попадают с материнским молоком, через окружающие предметы, воздушно-капельным путем от больного человека. Абсолютно неважно, в каком возрастном периоде произошло заражение. Наличие молочницы в микрофлоре никак не проявляется до ослабления иммунной защиты. Активное развитие паразитического гриба вызывает висцеральные поражения.
Диагностика
Успех лечения, его продолжительность, эффективность и возможные осложнения зависят от диагностики. Несколько специальных процедур безошибочно укажут на кандидоз ЖКТ. Диагностирование заболевания предполагает:
- Лабораторные исследования мазка из ротовой полости.
- Применение метода посева из частичек рвотных масс, который помогает определить наличие мицелия.
- Использование метода эндоскопии желудка. Это позволяет установить наличие белого налета, характерного для молочницы, определить его количество и природу, помогает оценить степень распространения инфекции.
- Проведение иммунологической реакции для определения антител, которые вырабатывает организм для борьбы с инфекцией.
Лечение кандидоза желудка
Комплекс мероприятий при молочнице желудка предполагает медикаментозное лечение, организацию диетического питания, выполнение посильных физических упражнений, использование народных методов. Лекарственные препараты и схему лечения назначает лечащий врач в зависимости от стадии заболевания и состояния пациента. При запущенных формах молочницы желудка требуется госпитализация. Цели лекарственной терапии:
- повышение и укрепление иммунитета;
- противогрибковое действие;
- ликвидация первопричины заболевания;
- антисептическое действие;
- устранение воспалительных процессов;
- оздоровление микрофлоры.
Лекарственная терапия включает применение нескольких групп препаратов. Противогрибковые лекарственные средства (Пимафуцин, Флуконазол, Леворин) оказывают направленное действие на уничтожение паразитического грибка. При тяжелых формах заболевания используются внутривенные инъекции Амфолипа и Амфотерицина. Препараты Линекс, Хилак-форте, Йогурт лечебный предназначены для восстановления микрофлоры.
С использованием лекарственных средств проводится симптоматическое лечение:
Пимафуцин оказывает сильное фунгицидное действие. Таблетки покрыты специальной кишечнорастворимой оболочкой. Стандартная схема приема для взрослых – по 1 таблетке 4 раза в день в течение 1 недели. Лекарство нужно запивать большим количеством воды. Неоспоримым плюсом препарата является местное действие в очаге инфекции, он не попадает в кровоток. У возбудителей инфекции не возникает привыкания к действующему веществу. Препарат не токсичен, сочетается с другими лекарственными средствами, противопоказан только при индивидуальной непереносимости компонентов.
Флуконазол хорошо зарекомендовал себя в схемах лечения молочницы ЖКТ. При поражениях пищеварительных органов курс лечения составляет около месяца при условии начала терапии на ранних стадиях заболевания. Лечение хронической инфекции длится около полугода. Флуконазол в этом случае применяется как основное лечебное средство и профилактическое. Суточная доза назначается в зависимости от степени тяжести заболевания и составляет от 150 до 400 мг. Капсулы (или таблетки) принимают целиком, запивают 1 стаканом воды, независимо от приема пищи.
Леворин является популярным противогрибковым препаратом, отзывы пациентов о нем преимущественно положительные. Выпускается лекарственное средство в виде таблеток, мази, гранул или порошка для приготовления суспензии. Последний вариант применяется в педиатрии. На начальных стадиях заболевания препарат оказывает быстрое терапевтическое действие. Средство простое в применении и доступное по цене. Взрослые принимают по 1 таблетке 2-4 раза в день, курсом 10-12 дней. Леворин лучше употреблять после еды.
Организация диетического питания занимает важное место в комплексной терапии кандидоза. Продукты, которые входят в рацион, способствуют прекращению развития паразитического грибка, и симптомы заболевания быстро исчезают. Кроме этого диета призвана отрегулировать работу пищеварительной системы, нормализовать массу тела у тех, для кого актуален этот вопрос. Лечебной диеты необходимо придерживаться в ходе терапии и две недели после ее окончания, это предотвращает рецидивы.
В списке запрещенных продуктов при кандидозе находятся:
- кондитерская выпечка;
- грибы;
- маринованные продукты;
- пряное, острое, жирное, копченое;
- сахар;
- изделия из шоколада;
- газировка;
- горчица, майонезы, кетчупы.
Все вышеперечисленные продукты создают благоприятную среду для развития мицелия гриба, поэтому должны быть категорически исключены из рациона. К этому списку не лишним будет добавить консервы, цитрусовые, спиртные напитки, квас, чай, кофе. Перечень ограничений внушительный, но и разрешенных продуктов немало:
- тушеные овощи, фрукты;
- облепиха, клюква, черника, брусника;
- зеленные овощи;
- отварное нежирное мясо и рыба;
- яйца,
- субпродукты (печень, почки);
- оливковое, льняное масло;
- каши (гречневая, рисовая);
- морская капуста;
- морковный сок и блюда из моркови;
- семена тыквы, кунжута;
- молочнокислые продукты (кефир, натуральные йогурты);
- травяные чаи.
Средства народной медицины оказывают лечебное действие только на ранних стадиях кандидоза. Их применение без консультации с врачом не рекомендуется. Самолечение может усугубить течение болезни. Особенно это касается острых запущенных форм молочницы желудка. Действенной мерой является употребление овсяных хлопьев, чеснока, настоев из дуба, календулы, чистотела, зверобоя, сока из моркови.
Противогрибковый растительный отвар можно приготовить из шалфея, коры дуба (порошок), полыни, золотарника, почек черного тополя (порошок). Все компоненты взять по 1 столовой ложке, залить 1 стаканом кипятка, греть на водяной бане 15 минут, остудить, пить по 30-40 мл натощак. Этим же отваром перед завтраком можно обрабатывать ротовую полость, процедура проводится 30-40 минут (набирать в рот, держать некоторое время, сплевывать и набирать новую порцию). Так уничтожаются споры гриба в ротовой полости и пищеводе, предупреждается повторное заражение и рецидив.
Эффективно борется с кандидозом свежевыжатый сок моркови. 1 стакан сока выпивают натощак. Противогрибковое действие оказывает аллицин чеснока. Полезно употребление нескольких зубчиков чеснока во время еды. Можно смешать 1 столовую ложку чеснока с 50-100 г свежего морковного сока или приготовить салат из 1 одной средней моркови и 2-3 зубчиков чеснока (его суточная лечебная дозировка составляет 12-15 зубчиков, к ней организм нужно приучать постепенно).
Последствия
Поздние стадии кандидоза могут вызвать эрозивный, катаральный гастрит. Симптомами этого состояния являются болевые ощущения в верхнем отделе желудка, рвота с кровью и белой слизью. Кандидоз в желудке может вызвать прободение стенки желудка, которое сопровождается кровотечением и развитием перитонита. При повреждении крупного кровеносного сосуда кровопотери могут быть значительными.
Кровотечения способствуют распространению спор гриба по всему организму, появляются дополнительные очаги инфекции, развивается анемия. Слизистые оболочки на поздних стадиях заболевания поражены очень глубоко, поэтому обычное медикаментозное лечение не эффективно. Терапевтические мероприятия предполагают прием более сильных препаратов или оперативное вмешательство.
Поврежденные ткани не способны противостоять патогенному воздействию. Кандидоз желудка провоцирует системные поражения кожи, по мере усугубления заболевания происходит присоединение инвазивных инфекций, заболеваний ЖКТ, которые вызываются бактериями. Совместное действие всех названных факторов на фоне ослабленной иммунной защиты может привести к летальному исходу.
Профилактика
Молочницу легче предупредить, чем лечить. Активизация Кандид происходит в результате ослабления иммунной защиты, поэтому профилактические мероприятия направлены на общее укрепление здоровья:
- принимать строго по назначению врача антибиотики и препараты, которые ослабляют микрофлору;
- следовать принципам здорового питания;
- практиковать профилактические курсы витаминных комплексов;
- нормализовать посильную двигательную активность;
- своевременно лечить воспаления и инфекции;
- не заниматься самолечением;
- регулярно проводить профилактику и лечение хронической язвы, гастрита, эрозии, чтобы избежать бесконтрольного роста бактерий и грибков;
- при острых проявлениях патологии обязательно проходить курс противогрибковой терапии.
Читайте также: